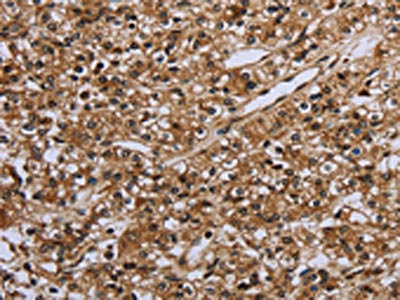

IL31RA Antibody
-
中文名稱:IL31RA兔多克隆抗體
-
貨號:CSB-PA107902
-
規格:¥1100
-
圖片:
-
The image on the left is immunohistochemistry of paraffin-embedded Human breast cancer tissue using CSB-PA107902(IL31RA Antibody) at dilution 1/20, on the right is treated with fusion protein. (Original magnification: ×200)
-
The image on the left is immunohistochemistry of paraffin-embedded Human prostate cancer tissue using CSB-PA107902(IL31RA Antibody) at dilution 1/20, on the right is treated with fusion protein. (Original magnification: ×200)
-
-
其他:
產品詳情
-
Uniprot No.:
-
基因名:
-
別名:Class I cytokine receptor antibody; CRL 3 antibody; CRL antibody; CRL3 antibody; Cytokine receptor like 3 antibody; Cytokine receptor-like 3 antibody; GLM R antibody; GLM-R antibody; GLMR antibody; Gp130 like monocyte receptor antibody; GP130 like receptor antibody; Gp130-like monocyte receptor antibody; Gp130-like receptor antibody; GPL antibody; HGLM R antibody; HGLM-R antibody; HGLMR antibody; IL 31 receptor subunit alpha antibody; IL 31R subunit alpha antibody; IL 31RA antibody; IL-31 receptor subunit alpha antibody; IL-31R subunit alpha antibody; IL-31R-alpha antibody; IL-31RA antibody; IL31 receptor subunit alpha antibody; IL31R subunit alpha antibody; IL31R_HUMAN antibody; IL31RA antibody; Interleukin 31 receptor A antibody; interleukin 31 receptor subunit alpha antibody; Interleukin-31 receptor subunit alpha antibody; MGC125346 antibody; PLCA 2 antibody; PLCA2 antibody; PRO21384 antibody; Soluble type I cytokine receptor CRL3 antibody; ZcytoR17 antibody
-
宿主:Rabbit
-
反應種屬:Human
-
免疫原:Fusion protein of Human IL31RA
-
免疫原種屬:Homo sapiens (Human)
-
標記方式:Non-conjugated
-
抗體亞型:IgG
-
純化方式:Antigen affinity purification
-
濃度:It differs from different batches. Please contact us to confirm it.
-
保存緩沖液:-20°C, pH7.4 PBS, 0.05% NaN3, 40% Glycerol
-
產品提供形式:Liquid
-
應用范圍:ELISA,IHC
-
推薦稀釋比:
Application Recommended Dilution ELISA 1:1000-1:2000 IHC 1:25-1:100 -
Protocols:
-
儲存條件:Upon receipt, store at -20°C or -80°C. Avoid repeated freeze.
-
貨期:Basically, we can dispatch the products out in 1-3 working days after receiving your orders. Delivery time maybe differs from different purchasing way or location, please kindly consult your local distributors for specific delivery time.
-
用途:For Research Use Only. Not for use in diagnostic or therapeutic procedures.
相關產品
靶點詳情
-
功能:Associates with OSMR to form the interleukin-31 receptor which activates STAT3 and to a lower extent STAT1 and STAT5. May function in skin immunity. Mediates IL31-induced itch, probably in a manner dependent on cation channels TRPA1 and TRPV1. Positively regulates numbers and cycling status of immature subsets of myeloid progenitor cells in bone marrow in vivo and enhances myeloid progenitor cell survival in vitro.
-
基因功能參考文獻:
- The first demonstration of the involvement of the IL-31/IL-31R axis in cancer came from studies in patients with mycosis fungoides/Sezary syndrome, the most frequent, cutaneous T cell lymphoma. Tumor cells were shown to produce IL-31, whose serum levels correlated with pruritus intensity. PMID: 28408397
- The interleukin IL-31/IL-31receptor axis contributes to tumor growth in human follicular lymphoma. PMID: 25283844
- detected in keratinocytes and nerve fibers in the dermis of atopic dermatitis and in the neurons of normal dorsal root ganglia PMID: 24667097
- IL31RA is a functional receptor expressed by a small subpopulation of IL-31RA(+)/TRPV1(+)/TRPA1(+) neurons and is a critical neuroimmune link between TH2 cells and sensory nerves for the generation of T cell-mediated itch. PMID: 24373353
- IL-31 and IL-31RA are upregulated in patients with allergic rhinitis, and induce MUC5AC gene expression in human airway epithelial cells. PMID: 23392388
- IFN-gamma-induced IL-31RA upregulation in dermal microvascular endothelium is processed via JNK and PI3 kinase activation PMID: 20849534
- The identification of OSMR and IL31RA gene pathology provides an explanation of the high prevalence of primary cutaneous amyloidosis in Taiwan as well as new insight into disease pathophysiology. PMID: 19690585
- A novel type I cytokine receptor is expressed on monocytes, signals proliferation, and activates STAT-3 and STAT-5. PMID: 11877449
- GPL is a novel cytokine receptor related to GP130 and leukemia inhibitory factor receptor PMID: 14504285
- the molecular mechanisms underlying GPL-mediated signal transduction PMID: 15194700
- IL-31 receptor alpha expression in epidermal keratinocytes is modulated by cell differentiation and interferon gamma PMID: 18580959
- ). Binding of IL-31 to its receptor activates Jak/STAT, PI3K/AKT and MAPK pathways.[review] PMID: 18926762
顯示更多
收起更多
-
相關疾病:Amyloidosis, primary localized cutaneous, 2 (PLCA2)
-
亞細胞定位:Cell membrane; Single-pass type I membrane protein. Cell junction, synapse, presynaptic cell membrane. Cell projection, axon.
-
蛋白家族:Type I cytokine receptor family, Type 2 subfamily
-
組織特異性:Expressed in CD14- and CD56-positive blood cells. Expressed in macrophages. Expressed in keratinocytes. Expressed in a subset of dorsal root ganglia neurons (at protein level). Expressed at low levels in testis, ovary, brain, prostate, placenta, thymus, b
-
數據庫鏈接:
Most popular with customers
-
-
YWHAB Recombinant Monoclonal Antibody
Applications: ELISA, WB, IHC, IF, FC
Species Reactivity: Human, Mouse, Rat
-
Phospho-YAP1 (S127) Recombinant Monoclonal Antibody
Applications: ELISA, WB, IHC
Species Reactivity: Human
-
-
-
-
-